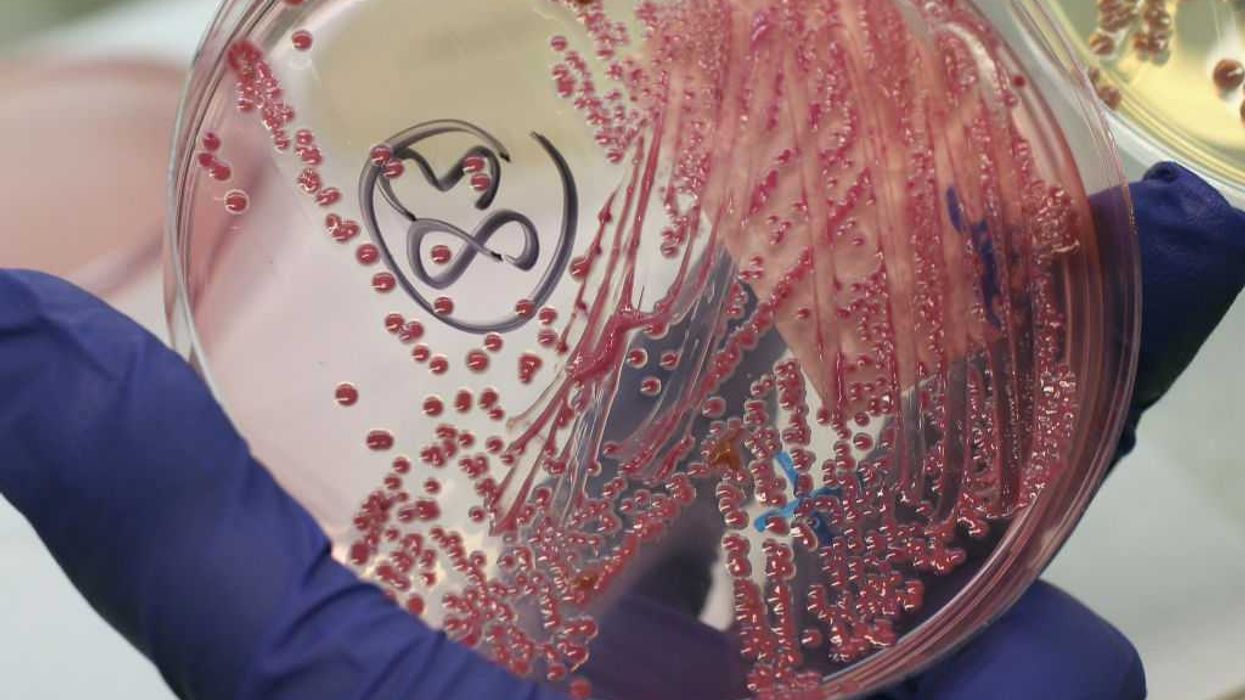

Another Chinese researcher busted for allegedly smuggling crop-harming biomaterial into America
Federal agents charged another Chinese national with allegedly trying to smuggle biological materials into the United States.
Live Your Best Retirement
Fun • Funds • Fitness • Freedom
On Friday morning, FBI Director Kash Patel announced that the agency had filed charges against Youhuang Xiang, a postdoctoral researcher who is in the country on a J-1 visa.
'To all universities and their compliance departments: Please be vigilant of this trend.'
These visas are issued to exchange visitors approved to participate in certain programs, such as studying or conducting research, according to U.S. Citizenship and Immigration Services. J-1 visas are provided to professors, research assistants, and students.
Xiang allegedly smuggled Escherichia coli, commonly referred to as E. coli, into the country. He is also accused of making false statements about the smuggling scheme.
Patel explained that E. coli, when not properly controlled, can "inflict devastating disease to U.S. crops and cause significant financial loss to the U.S. economy."
Xiang was listed on Indiana University's website as a postdoctoral fellow. His "research interests" included "recognition specificity in host-pathogen interactions and engineering crop resistance to pathogen," according to the website. As of Friday afternoon, the university removed Xiang from its Department of Biology webpage.
Kash Patel. Photo by Michael M. Santiago/Getty Images
"This is yet another example of a researcher from China — given the privilege to work at a U.S. university — who then allegedly chose to take part in a scheme to circumvent U.S. laws and receive biological materials hidden in a package originating from China," Patel wrote in a post on social media.
The FBI director noted that the agency and Customs and Border Protection partners "are committed to enforcing U.S. laws put in place to protect against this global threat to our economy and food supply."
RELATED: University of Michigan now under fire after Chinese scholars allegedly smuggle bio-weapon
Photo by Sean Gallup/Getty Images
"The FBI will not tolerate any attempt to exploit our nation's institutions for illegal activity — as we have seen in this case and the three Chinese nationals charged in Michigan in November for allegedly smuggling biological materials into the U.S. on several occasions," Patel continued. "The FBI and our partners are committed to defending the homeland and stopping any illegal smuggling into our country."
Patel was referring to several Chinese scholars from the University of Michigan who were accused earlier this year of being tied to a smuggling conspiracy. Some of the biological materials the individuals allegedly brought into the U.S. were described as potential agricultural terrorism weapons.
"To all universities and their compliance departments: Please be vigilant of this trend. Ensure your researchers know that there is a correct and legal way to obtain a license to import/export approved biological materials, and it must be followed without exception. Our continued partnerships will help to better secure our nation and ensure all parties are held accountable," Patel wrote.
Indiana University did not respond to a request for comment.
Like Blaze News? Bypass the censors, sign up for our newsletters, and get stories like this direct to your inbox. Sign up here!
What's Your Reaction?
Like
0
Dislike
0
Love
0
Funny
0
Wow
0
Sad
0
Angry
0
Comments (0)